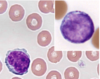

WBC morphology & function Flashcards
(32 cards)
Name the cell types


Name the cell type


Name the cell type


Name the cell types

In what species are lymphocytes not smaller than neutrophils?
bovines
Name the cell type

monocyte
Name the cell type & species.

Eosinophil, bovine- small, densely packed granules
Name the cell type & species.

eosinophil: canine- variable appearance
Name the cell type & species.

eosinophil: feline- rod shaped granules
Name the cell type & species.

eosinophil: equine- dense large granules
label the cell type and species.


What are the blood pools for neutrophils?
circulating, marginating, tissues
which species responds more readily to tissue demands for neutrophils
Canine
What is the ratio circulating pool: marginating pool in most species and then in felines?
most species: 50:50
felines: 30:70
What conditions/disease could alter the distribution of neutrophils across the different pools?
inflammation
stress
excitement
endotoxemia
What dictates time of neutrophils in circulation?
tissue demand for neutrophils
When is the time of neutrophils in circulation shortened?
inflammation
Describe the distribution of lymphocytes in the body?

What structure transports lymphocytes from l.n. back to circulation?
thoracic duct
What is the half-life of monocytes in blood? in tissues?
blood: 12hrs-3days
tissues: weeks-months
What inflammatory mediator is important for eosniphil chemoattraction and production?
IL-5
What cell is abnormal to observe in the blood?
mast cell
What cytopenias are clinically important?
neutropenia
lymphopenia
eosinopenia
Clinically important increases?
neutrophilia
eosinophilia
basophilia
monocytosis
lymphocytosis


